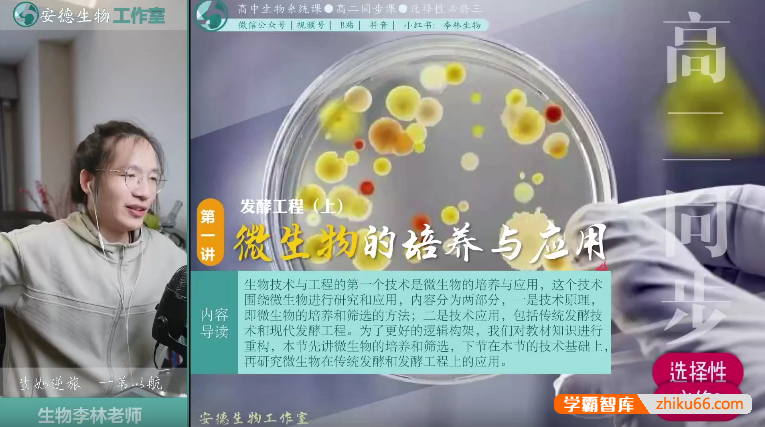
【李林生物】2025届安德高二生物 李林高二生物全年同步课(上学期+下学期)

名师简介:
李林/生物名师,笔名 安德 人称“德叔”,11年教龄,10万好评,注重思维能力培养。
授课时长超2000+小时,帮助百万学生有效提分。
构建独家高中生物完整教学体系,高中三年全程伴学。
10 年生物名师教学经验总结,高考生物科学备考 4 步法。
授课特点:
第一,知识点讲解透彻,思路清晰,是有多年高中生物教学经验的资深老师。
第二,特别有爱心。毫无保留的把他所知道的全部交给我们,无论是知识方面、解题方面甚至是备考方面。
第三,特别有耐心。每一次讲解完,学生提问的问题都能耐心解答。
课程目录(资源合计59.77GB):
【李林生物】26届高二全年同步课【独家、无水印版本】 ├─ 高二上 │ ├─ 【高二上】导学课 │ │ ├─ 高二上_导学课 │ │ │ ├─ 第0讲_导学课.pdf [13.04MB] │ │ │ ├─ 高二上_导学课.mp4 [395.01MB] │ ├─ 【高二上】能力培优 │ │ ├─ 第16讲_能力提升(一)_信息分析方法 │ │ │ ├─ 第16讲_能力提升(一)_信息分析方法.mp4 [1.15GB] │ │ ├─ 第17讲_能力提升(二)_长句表述方法 │ │ │ ├─ 第17讲_能力提升(二)_长句表述方法.mp4 [1.15GB] │ │ ├─ 第18讲_能力提升(三)_实验分析方法 │ │ │ ├─ 第18讲 能力提升(三) 实验分析方法 │ │ │ │ ├─ 第18讲 能力提升(三) 实验分析方法.mp4 [1.17GB] │ │ ├─ 第19讲_能力提升(四)_实验设计方法 │ │ │ ├─ 第19讲 能力提升(四) 实验设计方法.mp4 [951.64MB] │ ├─ 【高二上】期末复习 │ │ ├─ 高二上 期末复习 │ │ │ ├─ 高二上 期末复习.mp4 [1.23GB] │ ├─ 【高二上】期中复习【www.x ue -ba.org】 │ │ ├─ 高二上_期中复习 │ │ │ ├─ 高二上_期中复习.mp4 [1.08GB] │ ├─ 【高二上】人体的内环境与稳态 │ │ ├─ 第1讲_核心课_人体的内环境与稳态 │ │ │ ├─ 【回放指南】高二(上)核心课_第1讲.pdf [433.20kB] │ │ │ ├─ 第1讲_核心课_人体的内环境与稳态.mp4 [1.13GB] │ │ │ ├─ 第1讲_内环境与稳态(手写笔记).pdf [21.03MB] │ │ ├─ 第1讲_刷题课_人体的内环境与稳态 │ │ │ ├─ 第1讲_刷题课_人体的内环境与稳态.mp4 [530.49MB] │ │ │ ├─ 高二上_第1讲_人体的内环境与稳态-解析.pdf [961.97kB] │ │ ├─ 实验一:模拟生物体维持PH的稳定 │ │ │ ├─ 实验1__模拟生物维持pH的稳定(手写笔记).pdf [2.01MB] │ │ │ ├─ 实验一:模拟生物体维持PH的稳定.mp4 [112.65MB] │ ├─ 【高二上】生态学 │ │ ├─ 第10讲_核心课_种群数量的变化 │ │ │ ├─ 【回放指南】高二(上)核心课_第10讲.pdf [418.66kB] │ │ │ ├─ 第10讲_核心课_种群数量的变化.mp4 [1.10GB] │ │ │ ├─ 第10讲_种群数量的变化(手写笔记).pdf [14.31MB] │ │ ├─ 第10讲_刷题课_种群数量的变化 │ │ │ ├─ 第10讲_刷题课_种群数量的变化.mp4 [638.80MB] │ │ │ ├─ 高二上_第10讲_种群数量的变化-解析.pdf [1,008.48kB] │ │ ├─ 第11讲_核心课_群落及其演替 │ │ │ ├─ 【回放指南】高二(上)核心课_第11讲.pdf [422.57kB] │ │ │ ├─ 第11讲__群落及其演替(手写笔记).pdf [18.50MB] │ │ │ ├─ 第11讲_核心课_群落及其演替.mp4 [1.25GB] │ │ ├─ 第11讲_刷题课_群落及其演替 │ │ │ ├─ 第11讲_刷题课_群落及其演替.mp4 [643.25MB] │ │ │ ├─ 高二上_第11讲_群落及其演替-解析.pdf [982.86kB] │ │ ├─ 第12讲_核心课_生态系统的结构和能量流动 │ │ │ ├─ 【回放指南】高二(上)核心课_第12讲.pdf [425.83kB] │ │ │ ├─ 第12讲__生态系统的结构和能量流动.pdf [19.10MB] │ │ │ ├─ 第12讲_核心课_生态系统的结构和能量流动.mp4 [1.06GB] │ │ ├─ 第12讲_刷题课_生态系统的结构和能量流动 │ │ │ ├─ 第12讲_刷题课_生态系统的结构和能量流动.mp4 [444.43MB] │ │ │ ├─ 高二上_第12讲_生态系统的结构及能量流动-解析.pdf [909.46kB] │ │ ├─ 第13讲_核心课_生态系统的物质循环 │ │ │ ├─ 【回放指南】高二(上)核心课_第13讲.pdf [429.64kB] │ │ │ ├─ 第13讲__生态系统的其他功能及稳定性(手写笔记).pdf [17.56MB] │ │ │ ├─ 第13讲_核心课_生态系统的物质循环.mp4 [1.40GB] │ │ ├─ 第13讲_刷题课_生态系统的物质循环 │ │ │ ├─ 第13讲_刷题课_生态系统的物质循环.mp4 [602.74MB] │ │ │ ├─ 高二上_第13讲_生态系统的物质循环和信息传递-解析.pdf [1,006.10kB] │ │ ├─ 第14讲_核心课_生态系统题型归纳 │ │ │ ├─ 第14讲_核心课_生态系统题型归纳.mp4 [784.42MB] │ │ ├─ 第14讲_刷题课_生态系统题型归纳 │ │ │ ├─ 第14讲_刷题课_生态系统题型归纳.mp4 [455.08MB] │ │ ├─ 第9讲_核心课_种群及其数量特征 │ │ │ ├─ 【回放指南】高二(上)核心课_第9讲(1).pdf [421.75kB] │ │ │ ├─ 第9讲_核心课_种群及其数量特征.mp4 [1,021.78MB] │ │ │ ├─ 第9讲_种群的特征(手写笔记).pdf [16.45MB] │ │ ├─ 第9讲_刷题课_种群及其数量特征 │ │ │ ├─ 第9讲_刷题课_种群及其数量特征.mp4 [594.50MB] │ │ │ ├─ 高二上_第9讲_种群的数量特征-解析.pdf [899.41kB] │ │ ├─ 实验六:探究土壤微生物的分解作用设计制作生态缸,观察其稳定性 │ │ │ ├─ 实验六:探究土壤微生物的分解作用设计制作生态缸,观察其稳定性.mp4 [159.91MB] │ │ ├─ 实验三:调查草地中某种双子叶植物的种群密 │ │ │ ├─ 实验3__调查草地中某种双子叶植物的种群密度(手写笔记).pdf [2.01MB] │ │ │ ├─ 实验三:调查草地中某种双子叶植物的种群密.mp4 [122.17MB] │ │ ├─ 实验四:培养液中酵母菌种群数量的变化 │ │ │ ├─ 实验4__培养液中酵母菌种群数量的变化(1).pdf [3.06MB] │ │ │ ├─ 实验四:培养液中酵母菌种群数量的变化.mp4 [244.67MB] │ ├─ 【高二上】生物与环境信息题解题方法 │ │ ├─ 第15讲_核心课_生物与环境信息题解题方法 │ │ │ ├─ 第15讲_核心课_生物与环境信息题解题方法.mp4 [1.19GB] │ │ ├─ 第15讲_刷题课_生物与环境信息题解题方法 │ │ │ ├─ 第15讲_刷题课_生物与环境信息题解题方法.mp4 [1.05GB] │ ├─ 【高二上】稳态调节 │ │ ├─ 第2讲_核心课_神经调节 │ │ │ ├─ 【回放指南】高二(上)核心课_第2讲(1).pdf [425.13kB] │ │ │ ├─ 第2讲_核心课_神经调节.mp4 [1.05GB] │ │ │ ├─ 第2讲_神经调节基础_(手写笔记).pdf [39.94MB] │ │ ├─ 第2讲_刷题课_神经调节 │ │ │ ├─ 第2讲_刷题课_神经调节.mp4 [853.12MB] │ │ │ ├─ 高二上_第2讲_神经调节基础-解析(1).pdf [932.44kB] │ │ ├─ 第3讲_核心课_神经调节 │ │ │ ├─ 【回放指南】高二(上)核心课_第3讲(1).pdf [430.47kB] │ │ │ ├─ 第3讲_核心课_神经调节.mp4 [988.12MB] │ │ │ ├─ 第3讲_神经调节的原理(手写笔记).pdf [18.54MB] │ │ ├─ 第3讲_刷题课_神经调节 │ │ │ ├─ 第3讲_刷题课_神经调节.mp4 [694.73MB] │ │ │ ├─ 高二上_第3讲_神经调节的过程-解析(1).pdf [897.03kB] │ │ ├─ 第4讲_核心课_体液调节 │ │ │ ├─ 【回放指南】高二(上)核心课_第4讲.pdf [421.42kB] │ │ │ ├─ 第4讲_核心课_体液调节.mp4 [1,002.10MB] │ │ │ ├─ 第4讲_体液调节(手写笔记).pdf [36.35MB] │ │ │ ├─ 李林讲义.pdf [253.74kB] │ │ ├─ 第4讲_刷题课_体液调节 │ │ │ ├─ 第4讲_刷题课_体液调节.mp4 [824.29MB] │ │ │ ├─ 高二上_第4讲_体液调节-解析.pdf [925.91kB] │ │ ├─ 第5讲_核心课_三大调节 │ │ │ ├─ 【回放指南】高二(上)核心课_第5讲(1).pdf [424.62kB] │ │ │ ├─ 第5讲_核心课_三大调节.mp4 [949.66MB] │ │ │ ├─ 第5讲_三大调节模型(手写笔记).pdf [15.87MB] │ │ ├─ 第5讲_刷题课_三大调节 │ │ │ ├─ 第5讲_刷题课_三大调节.mp4 [579.61MB] │ │ │ ├─ 高二上_第5讲_三大调节模型-解析(1).pdf [907.53kB] │ │ ├─ 第6讲_核心课_免疫调节 │ │ │ ├─ 【回放指南】高二(上)核心课_第6讲(1).pdf [421.44kB] │ │ │ ├─ 第6讲_核心课_免疫调节.mp4 [1.16GB] │ │ │ ├─ 第6讲_免疫调节(手写笔记).pdf [30.95MB] │ │ ├─ 第6讲_刷题课_免疫调节 │ │ │ ├─ 第6讲_刷题课_免疫调节.mp4 [808.72MB] │ │ │ ├─ 高二上_第6讲__免疫调节-解析(1).pdf [914.92kB] │ ├─ 【高二上】稳态与调节信息题解题方法 │ │ ├─ 第8讲_核心课_稳态与调节信息题解题方法 │ │ │ ├─ 【回放指南】高二(上)核心课_第8讲.pdf [413.37kB] │ │ │ ├─ 第8讲__稳态与调节信息分析(手写笔记).pdf [10.86MB] │ │ │ ├─ 第8讲_核心课_稳态与调节信息题解题方法.mp4 [939.99MB] │ │ ├─ 第8讲_刷题课_稳态与调节信息题解题方法 │ │ │ ├─ 11 高考加油.url [111B] │ │ │ ├─ 11年学霸网.url [123B] │ │ │ ├─ 第8讲_刷题课_稳态与调节信息题解题方法.mp4 [955.24MB] │ │ │ ├─ 高二上_第8讲_稳态与调节信息分析【www.x ue -ba.org】.pdf [1.13MB] │ ├─ 【高二上】知识体系构建 │ │ ├─ 第20讲 选择性必修1_2知识体系构建 │ │ │ ├─ 第20讲 选择性必修1_2知识体系构建.mp4 [844.65MB] │ ├─ 【高二上】植物生命活动的调节 │ │ ├─ 第7讲_核心课_植物生命活动的调节 │ │ │ ├─ 【回放指南】高二(上)核心课_第7讲.pdf [430.64kB] │ │ │ ├─ 第7讲__植物生命活动的调节_(手写笔记).pdf [32.92MB] │ │ │ ├─ 第7讲_核心课_植物生命活动的调节.mp4 [1.15GB] │ │ ├─ 第7讲_刷题课_植物生命活动的调节 │ │ │ ├─ 第7讲_刷题课_植物生命活动的调节.mp4 [595.89MB] │ │ │ ├─ 高二上_第7讲_植物生命活动的调节-解析.pdf [5.89MB] │ │ ├─ 实验二:探究植物生长调节剂的应用 │ │ │ ├─ 实验2__探究植物生长调节剂的应用_(手写笔记).pdf [3.48MB] │ │ │ ├─ 实验二:探究植物生长调节剂的应用.mp4 [168.53MB] ├─ 高二下 │ ├─ 【高二下】发酵工程 │ │ ├─ 【刷题】第1讲 微生物的培养技术及应用 │ │ │ ├─ 【刷题】第1讲 微生物的培养技术及应用.mp4 [666.98MB] │ │ ├─ 【刷题】第2讲 传统发酵技术与发酵工程 │ │ │ ├─ 【刷题】第2讲 传统发酵技术与发酵工程.mp4 [983.64MB] │ │ ├─ 第1讲 微生物的培养技术及应用 │ │ │ ├─ 第1讲 发酵工程(上)手写笔记.pdf [30.61MB] │ │ │ ├─ 第1讲 微生物的培养技术及应用.mp4 [1.03GB] │ │ ├─ 第2讲 传统发酵技术与发酵工程 │ │ │ ├─ 第2讲 传统发酵技术与发酵工程.mp4 [1.27GB] │ │ ├─ 实验一 ①酵母菌的纯培养 ②土壤中分解尿素的细菌的分离和计数 │ │ │ ├─ 实验课第1、2讲手写笔记.pdf [18.74MB] │ │ │ ├─ 实验一 ①酵母菌的纯培养 ②土壤中分解尿素的细菌的分离和计数.mp4 [489.52MB] │ ├─ 【高二下】基因工程 │ │ ├─ 【刷题】第10讲 基因工程的拓展 │ │ │ ├─ 【刷题】第10讲 基因工程的拓展.mp4 [957.98MB] │ │ ├─ 【刷题】第6讲 基因工程的工具 │ │ │ ├─ 【刷题】第6讲 基因工程的工具.mp4 [711.03MB] │ │ │ ├─ 第6讲 基因工程(一)(刷题课).pdf [4.39MB] │ │ │ ├─ 讲义.pdf [253.74kB] │ │ ├─ 【刷题】第7讲 基因工程的技术 │ │ │ ├─ 【刷题】第7讲 基因工程的技术.mp4 [970.23MB] │ │ │ ├─ 第7讲 基因工程(二)(刷题课).pdf [1.31MB] │ │ ├─ 【刷题】第8讲 基因工程的步骤 │ │ │ ├─ 【刷题】第8讲 基因工程的步骤.mp4 [586.39MB] │ │ │ ├─ 第8讲 基因工程(三) (刷题课).pdf [1.60MB] │ │ ├─ 【刷题】第9讲 基因工程的应用 │ │ │ ├─ 【刷题】第9讲 基因工程的应用.mp4 [525.16MB] │ │ ├─ 第10讲 基因工程的拓展 │ │ │ ├─ 第10讲 基因工程的拓展.mp4 [1.36GB] │ │ ├─ 第6讲 基因工程的工具 │ │ │ ├─ 【回放指南】高二(下) 核心课 第6讲.pdf [1.37MB] │ │ │ ├─ 第6讲 基因工程(一).pdf [29.02MB] │ │ │ ├─ 第6讲 基因工程的工具.mp4 [1.32GB] │ │ ├─ 第7讲 基因工程的技术 │ │ │ ├─ 【回放指南】高二(下) 核心课 第7讲.pdf [1.40MB] │ │ │ ├─ 第7讲 基因工程(二).pdf [27.11MB] │ │ │ ├─ 第7讲 基因工程的技术.mp4 [1.14GB] │ │ ├─ 第8讲 基因工程的步骤 │ │ │ ├─ 第8讲 基因工程的步骤.mp4 [1.22GB] │ │ ├─ 第9讲 基因工程的应用 │ │ │ ├─ 第9讲 基因工程的应用.mp4 [1.40GB] │ ├─ 【高二下】零轮复习 │ │ ├─ 第11讲 必修一知识体系和重点精讲 │ │ │ ├─ 第11讲 必修一知识体系和重点精讲.mp4 [1.09GB] │ │ ├─ 第12讲 必修二知识体系和重点精讲 │ │ │ ├─ 第12讲 必修二知识体系和重点精讲.mp4 [927.00MB] │ │ ├─ 第13讲 选必一知识体系和重点精讲 │ │ │ ├─ 第13讲 选必一知识体系和重点精讲.mp4 [997.88MB] │ ├─ 【高二下】细胞工程 │ │ ├─ 【刷题】第3讲 植物细胞工程 │ │ │ ├─ 【刷题】第3讲 植物细胞工程.mp4 [984.99MB] │ │ ├─ 【刷题】第4讲 动物细胞工程 │ │ │ ├─ 【刷题】第4讲 动物细胞工程.mp4 [1,006.80MB] │ │ ├─ 第3讲 植物细胞工程 │ │ │ ├─ 第3讲 植物细胞工程.mp4 [1.39GB] │ │ ├─ 第4讲 动物细胞工程 │ │ │ ├─ 第4讲 动物细胞工程.mp4 [1.36GB] │ │ ├─ 第5讲 胚胎工程 │ │ │ ├─ 第5讲 胚胎工程.mp4 [1.21GB] │ │ ├─ 实验三_ 菊花的组织培养 │ │ │ ├─ 实验课第4讲 菊花的组织培养.pdf [9.73MB] │ │ │ ├─ 实验三_ 菊花的组织培养.mp4 [113.59MB] │ ├─ 高(二)下期中课 │ │ ├─ 高二(下)期中课 │ │ │ ├─ 高二(下) 生物期中测试卷.pdf [6.16MB] │ │ │ ├─ 高二(下) 生物期中测试卷(答案+解析).pdf [5.28MB] │ │ │ ├─ 高二(下)期中课.mp4 [1.02GB]
版权声明:
・本站所有资源均来自网友分享及网络收集整理,仅供学习参考,版权归原作者所有!
・若您的权利被侵犯,请邮件告知haoke100@yeah.net,本站将及时予与删除并致以最深的歉意。
・本站所有资源均来自网友分享及网络收集整理,仅供学习参考,版权归原作者所有!
・若您的权利被侵犯,请邮件告知haoke100@yeah.net,本站将及时予与删除并致以最深的歉意。